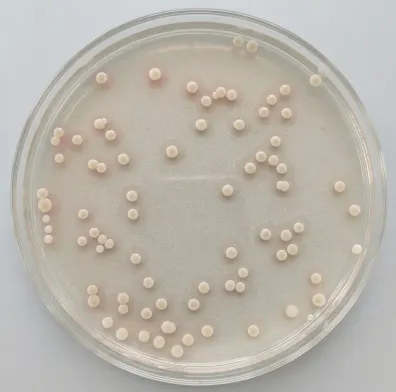
2026届北京市西城区高三一模测试试卷生物 第8张 2026届北京市西城区高三一模测试试卷生物 第8张

2026届北京市西城区高三统一测试试卷
生物
一、单选题
1.对人血红蛋白的叙述错误的是( )
A.由C、H、O、N等元素构成
B.组成血红蛋白的肽链在核糖体合成
C.肽链的氨基酸序列决定其空间结构
D.通过主动运输分泌到血浆中发挥运输作用
2.香樟幼树的光合速率与环境CO2浓度、土壤水分含量的关系如图。下列分析错误的是( )

A.a点光合速率大于b点与气孔导度较大有关
B.bc段限制光合作用的主要因素是CO2浓度
C.干旱胁迫会降低香樟幼树同化CO2的能力
D.水分缺乏还影响香樟对土壤无机盐的利用
3.我国科研人员开发的通用型iPS衍生帕金森病细胞治疗产品(多巴胺能神经前体细胞)已进入临床阶段。相关叙述错误的是( )
A.诱导形成iPS细胞过程中不存在基因选择性表达
B.iPS细胞具有自我更新能力和多向分化的潜能
C.应用iPS细胞避免了胚胎干细胞涉及的伦理问题
D.通用型iPS衍生细胞治疗产品具有即时供应的优势
4.Fabry病是伴X染色体隐性遗传病。患者编码α-半乳糖苷酶A的基因GLA发生突变,导致Gb3等在全身多个脏器积累,引起临床症状。相关叙述正确的是( )
A.Fabry病患者中女性远多于男性
B.所有患者GLA的碱基序列均相同
C.基因测序、Gb3含量测定可辅助诊断
D.可通过口服α-半乳糖苷酶进行治疗
5.酵母有α型和a型两种交配类型,由一对等位基因决定。3号染色体上的R基因使酵母有环己酰亚胺(CYH)抗性。利用2个酵母细胞进行实验,结果如图。不考虑突变,由结果可得出( )

A.子囊中四个细胞的基因型两两相同
B.R基因参与决定酵母交配类型
C.减数分裂时发生了同源染色体片段交换
D.筛选获得的酵母细胞基因型均为RR
6.将来自不同湖泊的刺鱼在人工饲养条件下杂交,结果如图。对两个刺鱼种群的叙述错误的是( )

A.不存在生殖隔离B.性状主要由环境决定
C.基因库有差异D.具有共同祖先
7.不同选择压力下,某种生物在繁殖、竞争和避免被捕食之间的能量分配比例如图。相关分析错误的是( )

A.生物用于繁殖、竞争和避免被捕食的能量之和等于其同化的总能量
B.低竞争低捕食条件更有利于种群数量增长
C.环境从A到C变化时,能量分配调整有利于降低死亡率
D.新迁入某地的种群,能量分配可发生由A到B再到D的变化
8.某湖泊受到低水平原子能工业废料污染后,湖中的食物网各部分锶-90的相对含量如图所示。下列分析错误的是( )

A.水生植物属于第一营养级
B.浮游动物中锶-90含量可能低于750
C.锶-90不易被排出体外使其沿着食物链在生物体内富集
D.引入水生植物清除湖中锶-90体现了生物多样性的直接价值
9.下列生态工程设计中,依据的主要原理不是“循环”的是( )
A.生态农场利用秸秆培养食用菌,菌渣再还田
B.桑基鱼塘中用蚕沙喂鱼、塘泥培桑
C.厨余垃圾堆肥发酵,制成有机肥用于城市绿化
D.在塔克拉玛干沙漠锁边工程中,选种多种本土植物
10.慢性失眠会使肾上腺皮质分泌皮质醇增多,进而产生疲劳、焦虑等症状。推拿治疗对患者下丘脑-垂体-肾上腺皮质轴(HPA轴)的影响如表。相关叙述错误的是( )
组别 | 时间 | 皮质醇 (pg·mL-1) | 促肾上腺皮质激素 (pg·mL-1) | 促肾上腺皮质激素释放激素 (pg·mL-1) |
健康组 | 1486 | 298 | 187 | |
推拿组 | 治疗前 | 1996 | 330 | 213 |
治疗后 | 1571 | 300 | 190 |
A.患者皮质醇较高与下丘脑产生的促肾上腺皮质激素较高有关
B.推拿治疗可以降低慢性失眠患者HPA轴相关激素的水平
C.推拿治疗可能促进了皮质醇对垂体的反馈抑制作用
D.还应检测睡眠质量、疲劳状态等指标来评价疗效
11.调节性T细胞是一类免疫抑制细胞,可抑制辅助性T细胞和细胞毒性T细胞的活化、增殖。在下列疾病的治疗中,抑制调节性T细胞活性有利于减轻症状的是( )
A.自身免疫病B.癌症
C.移植排斥反应D.过敏反应
12.GSK是油菜素内酯(BR)信号通路中的关键组分。生长素响应基因OsIAA7调控水稻籽粒发育(如图)。以下说法错误的是( )

A.生长素和BR共同调控水稻籽粒的大小
B.OsIAA7增强GSK对BZR的磷酸化修饰
C.Osiaa7突变体中过表达GSK可使籽粒更大
D.该研究可为水稻高产育种提供新靶点
13.为制备抗甲肝抗原的人源单克隆抗体,从病毒携带者的淋巴细胞获取抗体基因,通过基因工程使抗体展示在噬菌体表面,从中筛选携带目标抗体的噬菌体克隆。此过程中不需要的步骤是( )
A.设计引物,通过PCR获取抗体基因
B.将分离的B细胞与骨髓瘤细胞融合并筛选
C.构建抗体基因—噬菌体表面蛋白基因融合基因
D.通过抗原—抗体杂交对噬菌体抗体库进行筛选
14.某同学探究公园土壤中分解尿素的细菌的数量,部分结果如图。相关叙述正确的是( )
A.培养基以尿素为唯一碳源
B.采用平板划线法进行接种
C.用无菌水对土壤浸出液进行梯度稀释
D.菌落太少,不适合分解尿素细菌的计数
15.关于实验中温度的控制,叙述错误的是( )
A.PCR扩增DNA片段,变性后需要降低温度以复性
B.诱导洋葱细胞染色体数目加倍,可将洋葱放置在4℃环境
C.体外培养哺乳动物细胞,温度多以(36.5±0.5)℃为宜
D.用双缩脲试剂检测蛋白质,需将试管放入沸水中加热
二、解答题
16.种间关系及其维持机制是生态学研究的重点问题。科研人员对蝇子草与夜蛾等传粉昆虫之间的互作关系进行了研究。
(1)生物学在不同结构层次上研究的问题不同。种间关系属于_____水平研究的问题。
(2)夜蛾成虫夜间活动,熊蜂白天出巢访花。为确定蝇子草与夜蛾、熊蜂等的传粉关系,在不同时间段对蝇子草的花进行套袋,一段时间后统计坐果率,结果如图。

①细蝇子草昼夜全套组的坐果率_____其他三组,说明其高度依赖动物传粉。
②观察发现,云南蝇子草的花中有夜蛾卵,部分果实被夜蛾幼虫啃食。图中结果表明夜蛾_____。研究者据此判断,夜蛾与云南蝇子草的种间关系为寄生。
(3)细蝇子草释放挥发性化学物质吸引夜蛾传粉,该实例体现了生态系统中_____对于种群繁衍的重要作用。在授粉后,细蝇子草释放的气味中对传粉者具有主要吸引作用的丁香醛等物质含量显著下降,细蝇子草通过这种机制限制了夜蛾在每朵花中的产卵数量。请分析限制单花产卵数有利于维持二者互惠关系的原因_____。
17.激酶VLK是一种分泌蛋白,可对蛋白质中的酪氨酸残基进行磷酸化修饰。研究发现VLK对痛觉感知至关重要。
(1)人体在受到机械损伤时,感觉神经元产生的_____传导至突触小体,引发VLK分泌到胞外。
(2)受体N和蛋白E广泛存在于大脑和脊髓兴奋性突触的突触后膜上。受体N是调节痛觉的关键因子,VLK可通过激活受体N增强人体对机械损伤的敏感性。根据相关研究,研究者假设:VLK可诱导E与N相互作用。为检验假设,在培养的人脊髓突触体中分别加入VLK、VLK和PAP(去磷酸化酶),一段时间后使用PLA技术(图1)进行检测,结果如图2。

图2所示结果支持假设,依据是_____。
(3)蛋白E第504位酪氨酸(电中性)被VLK磷酸化后带负电。以体外培养的人胚肾细胞为材料进行实验(如下表),证明了蛋白E第504位氨基酸位点的负电荷是E与N相互作用的必要且充分条件。请补充完善下表。
组别 | 人胚肾细胞(表达以下蛋白E) | 实验过程 | 检测结果 |
1 | 野生型蛋白E | ①敲低细胞内源VLK基因。 ②甲组细胞导入含VLK基因的表达载体,乙组细胞导入含功能缺失突变型VLK基因的表达载体。 ③一段时间后,用PLA技术检测荧光强度。 | 甲有较强红色荧光,乙无红色荧光 |
2 | 蛋白E第504位氨基酸替换为电中性的苯丙氨酸(不可被VLK磷酸化) | _____ | |
3 | 蛋白E第504位氨基酸替换为_____的氨基酸 | _____ |
(4)VLK基因主要在痛觉神经元中表达。请说明以VLK作为靶点的止痛药相较于氯胺酮(受体N阻断剂)类止痛药的优势_____。
18.肝脏中的肝星状细胞(HSC)被激活会引起肝纤维化,甚至发展为肝硬化、肝细胞癌。研究HSC的激活机制有助于防治相关疾病。
(1)HSC的激活和增殖依赖于有氧糖酵解代谢(图1)。在有氧条件下,葡萄糖在HSC的_____中被P酶等分解为丙酮酸,继而在L酶作用下被还原成乳酸。有氧糖酵解能更快产生中间代谢产物和ATP,以满足细胞快速增殖的需求。

(2)已有研究发现,Wnt蛋白与细胞膜上受体结合后,促进β连环蛋白进入细胞核,进而激活靶基因转录,该信号通路参与调节HSC有氧糖酵解。用Wnt蛋白处理HSC后,检测HSC中_____,结果如图2。研究者由此推测,Wnt/β连环蛋白信号通路对L酶基因表达进行直接调节,进而间接调节P酶基因表达。对L酶基因的进一步研究证实,L酶基因是β连环蛋白的直接靶基因。

(3)H蛋白是一种转录因子。用Wnt蛋白处理HSC,细胞中H蛋白总量及细胞核中H蛋白含量均提高。用蛋白质合成阻断剂环己亚胺处理HSC,检测细胞中H蛋白含量,结果如图3。该结果表明_____。

(4)L酶能与H蛋白结合并促进其进入细胞核,激活P酶基因和L酶基因转录。请综合以上信息,说明HSC能够被快速激活的主要原因_____。
(5)依据该研究结果推测,可利用_____来抑制HSC激活进而防治肝纤维化。
19.肿瘤细胞可分泌乳酸,肿瘤微环境中乳酸积累会减弱细胞毒性T淋巴细胞(Tc细胞)的杀伤能力。
(1)从免疫系统的功能分析,肿瘤微环境中乳酸积累可帮助肿瘤细胞逃避_____。
(2)Tc细胞可通过分泌肿瘤坏死因子(TNF)等发挥杀伤作用。用M蛋白抑制剂、乳酸处理活化的Tc细胞,分选高表达TNF的Tc细胞,结果如图1所示(数值为高表达TNF的Tc细胞占全部Tc细胞的百分比)。结果表明乳酸可通过M蛋白抑制Tc细胞活性,依据是_____。

(3)为探究M蛋白抑制Tc细胞活性的机制,利用甲乙丙三种转基因小鼠,通过杂交和筛选,获得仅在T细胞中M基因被敲除且T细胞能表达特定抗原受体D的小鼠。

注:LoxP为一段特殊的DNA序列,被A基因编码的重组酶识别并剪切后,两个LoxP之间的序列将被删除。T启动子是T细胞特异性启动子。D基因编码的抗原受体能够特异性识别卵清蛋白肽段。
①获取基因型为_____的纯合小鼠作为实验组。
②提取实验组和对照组小鼠Tc细胞,用_____处理以活化Tc细胞。检测小鼠活化的Tc细胞膜上葡萄糖转运蛋白1(GLUT1)的含量,结果如图3所示。

(4)综合以上研究,补充完善乳酸减弱Tc细胞杀伤能力的机制。乳酸促进Tc细胞M基因表达→_____→Tc细胞的肿瘤杀伤能力减弱。
20.玉米中A基因编码的蛋白质与花青素合成有关。正常表达A基因的玉米能合成花青素,茎呈紫色。无花青素玉米茎为绿色。

(1)将三个不同品系的玉米杂交,结果如图1。根据杂交实验1可知_____为显性性状。
(2)为解释杂交实验2的结果,进行一系列实验。将编码去甲基化酶的R基因导入品系乙,获得纯合转基因品系丁,丁表现为绿茎,R基因与A基因不在同一对染色体上。将品系丙与品系丁杂交,结果如图2。推测品系丙表现为绿茎的原因是_____。

(3)以杂交实验3中的F2紫茎植株为母本,以品系丙为父本进行杂交,单株收获种子。每个单株上收获的种子种植后形成的植株群为一个BCF群。在全部BCF群中,全绿茎BCF群占1/4,该群玉米与R/r相关的基因型为_____。
(4)将杂交实验2中F1与品系甲连续多代回交,子代均为绿茎。综合上述实验结果,推测杂交实验2中F1全为绿茎的原因是_____。用杂交实验2中的F1与品系乙杂交,若实验结果为_____,则支持上述假设。
21.学习以下材料,回答(1)~(5)题。
基于T7-OR复制系统的基因持续超突变和加速进化
T7噬菌体侵染大肠杆菌后,会合成其特有的DNA聚合酶、解旋酶等,以适配自身DNA的特殊结构,来进行DNA复制。科研人员对T7噬菌体的复制系统进行改造,开发出新的复制系统(T7-OR),实现了目标基因在大肠杆菌细胞内的连续超突变和加速进化。
T7溶菌酶的核心功能是降解宿主菌细胞壁,帮助子代噬菌体从细菌中释放。T7溶菌酶还参与T7噬菌体DNA复制(图1)。科研人员将T7DNA聚合酶基因、T7溶菌酶基因改造后,与T7RNA聚合酶基因、T7复制原点等导入大肠杆菌中,获得具有T7-OR复制系统的菌株(R菌株)。T7-OR系统仅作用于携带T7复制原点的环形质粒,实现在正常培养条件下目标基因的持续超突变。
细菌产生的β-内酰胺酶能够水解β-内酰胺类抗生素,使其失去抗菌活性。这种酶是细菌耐药性的重要机制之一。科研人员将β-内酰胺酶基因导入R菌株,然后将此菌株接种到含有最低抑菌浓度的抗生素的平板上,以此作为进化起点。培养后挑取菌落,在不断提高的抗生素浓度下传代培养。该系统仅用一周时间,就使β-内酰胺酶的抗菌活性提升5000倍,且进化出的突变位点与临床耐药菌株中的突变高度一致。

(1)在复制原点附近,T7溶菌酶与T7RNA聚合酶结合后______过程被终止,已合成的RNA链被T7DNA聚合酶利用,以复制T7DNA。
(2)为实现目标基因在宿主菌内的持续超突变,在开发T7-OR复制系统时,对T7溶菌酶和T7DNA聚合酶的改造分别是______。
(3)获取用于β-内酰胺酶基因加速进化的R菌株时,下列组件应构建到图2中哪种结构上。

①T7DNA聚合酶基因______;
②T7复制原点______;
③β-内酰胺酶基因______。
(4)关于β-内酰胺酶进化实验和T7-OR复制系统的叙述,正确的有______。
A.目标基因快速高频突变,依赖系统导致的高突变率和大肠杆菌快速繁殖能力
B.该系统使酶活性提升5000倍,说明可通过定向突变提升蛋白质功能
C.进化出的突变位点与临床耐药菌高度一致,体现实验室进化结果的实用性
(5)请说明T7-OR复制系统与传统诱变相比在基因加速进化方面的优势______。
《2026届北京市西城区高三统一测试试卷 生物》参考答案
题号 | 1 | 2 | 3 | 4 | 5 | 6 | 7 | 8 | 9 | 10 |
答案 | D | B | A | C | C | B | A | D | D | A |
题号 | 11 | 12 | 13 | 14 | 15 | |||||
答案 | B | C | B | C | D |
1.D
【详解】A、血红蛋白属于含铁的蛋白质,蛋白质的基本组成元素为C、H、O、N,A正确;
B、核糖体是蛋白质的合成场所,组成血红蛋白的肽链是在核糖体上经氨基酸脱水缩合形成的,B正确;
C、蛋白质的空间结构由氨基酸的种类、数目、排列顺序(即肽链的氨基酸序列)和肽链的盘曲、折叠方式共同决定,C正确;
D、血红蛋白是胞内蛋白,存在于红细胞内,在红细胞中发挥运输O₂等功能,不会分泌到血浆中;且分泌蛋白向外运输的方式为胞吐,不属于主动运输,D错误。
2.B
【详解】A、 a点对应水分正常条件,b点对应重度干旱条件;干旱时植物为减少失水会降低气孔导度,水分正常的a点气孔导度更大,CO2供应更充足,因此光合速率更大,A正确;
B、bc段随CO2浓度升高,光合速率基本不再增加,说明此时限制光合作用的主要因素是水分(干旱胁迫),不是CO2浓度,B错误;
C、相同CO2浓度下,干旱程度越高,香樟光合速率越低,说明干旱胁迫会降低香樟同化CO2的能力,C正确;
D、土壤中的无机盐需要溶解在水中才能被植物吸收,同时水分缺乏会影响植物根的呼吸作用、蒸腾作用,进而影响无机盐的吸收和运输,因此水分缺乏会影响香樟对土壤无机盐的利用,D正确。
3.A
【详解】A、诱导iPS细胞是将高度分化的体细胞重编程为多能干细胞的过程,该过程会开启多能性相关基因的表达、关闭体细胞特异性基因的表达,存在基因选择性表达,A错误;
B、iPS细胞属于诱导多能干细胞,具备干细胞的特性,既能够自我更新维持细胞群体数量,也具有多向分化的潜能,可分化为多种功能细胞,B正确;
C、胚胎干细胞需从早期胚胎中获取,涉及胚胎伦理争议,iPS细胞由普通体细胞诱导获得,不需要使用胚胎,避免了胚胎干细胞涉及的伦理问题,C正确;
D、通用型iPS衍生细胞治疗产品可预先规模化制备,无需针对患者单独定制,因此具有即时供应的优势,D正确。
4.C
【详解】A、伴X染色体隐性遗传病的遗传特点为男性患者远多于女性患者,男性仅含1条X染色体,只要携带致病基因就会发病,女性需要2条X染色体均携带致病基因才会发病,A错误;
B、基因突变具有不定向性,GLA基因可发生多种不同类型的突变导致患病,因此不同患者的GLA基因碱基序列不一定相同,B错误;
C、该病的病因是GLA基因突变,且病理特征为Gb3异常积累,因此通过基因测序检测是否存在致病突变、测定Gb3含量是否异常,都可以辅助诊断该病,C正确;
D、α-半乳糖苷酶的化学本质是蛋白质,口服后会被消化道中的蛋白酶分解失活,无法发挥生理作用,因此不能通过口服的方式治疗,D错误。
5.C
【详解】A、若在减数第一次分裂前期,同源染色体的非姐妹染色单体发生互换,子囊中4个单倍体细胞的基因型为R-a、R-α、r-a、r-α,4种基因型各不相同,A错误;
B、题目明确说明“交配类型由一对等位基因决定”,R/r基因仅控制CYH抗性,与交配型的遗传无关,B错误;
C、若减数分裂不发生互换,减数分裂仅产生R-α(抗CYHα型)和r-a(不抗CYHa型)两种配子,经CYH筛选后只有R-α(α型)存活;而实验结果为筛选后存活个体a型:α型=1:1,说明发生了同源染色体的互换,产生了R-a型配子,因此该推论成立,C正确;
D、筛选获得的酵母是单倍体(n),基因型为R,D错误。
6.B
【详解】A、两个刺鱼种群杂交可得到可育后代(F1可繁殖,F2正常出现性状分离),说明二者不存在生殖隔离,A正确;
B、根据杂交结果,F1相互交配后,F2性状分离比接近9:3:3:1,说明该性状由核基因控制、遵循孟德尔遗传规律,性状主要由遗传物质(基因)决定,B错误;
C、两个种群来自不同湖泊,原始性状存在差异,种群的基因库存在差异,C正确;
D、二者均为刺鱼,可杂交产生可育后代,说明亲缘关系较近,具有共同祖先,D正确。
7.A
【详解】A、生物同化的总能量除用于繁殖、竞争、避免被捕食外,还会通过呼吸作用以热能散失,因此三者之和小于同化总量,A错误;
B、由图可知,低竞争低捕食条件更有利于种群数量增长,因为此时用于繁殖的能量比例较高,有利于种群数量快速增长,B正确;
C、从A到C用于避免被捕食的能量比例增加,有助于减少被捕食风险从而降低死亡率,C正确;
D、新迁入种群初期可能面临低竞争低捕食,随着种群数量增加竞争加剧,随后捕食压力也可能增大,故新迁入某地的种群,能量分配可发生由A到B再到D的变化,D正确。
8.D
【详解】A、水生植物是自养型生物,属于生产者,在食物链中为第一营养级,A正确;
B、生物富集规律为:营养级越高,生物体内难以分解的有害物质含量越高。图中物质流动方向为:浮游动物→蛤,说明蛤以浮游动物为食,营养级高于浮游动物,蛤的锶-90含量为750,因此浮游动物的锶-90含量低于750,B正确;
C、锶-90属于难以被生物分解、排出体外的放射性物质,会沿食物链逐渐在生物体内富集,营养级越高含量越高,符合图中规律,C正确;
D、利用水生植物净化水体、清除污染物,属于生态系统的生态功能,体现的是生物多样性间接价值,不是直接价值,D错误。
9.D
【详解】A、生态农场用秸秆培养食用菌,菌渣还田后被农作物重新吸收利用,实现了物质的分层分级循环利用,符合循环原理,A不符合题意;
B、桑基鱼塘中蚕沙作为鱼的饵料,塘泥中的养分回归桑树被利用,实现了物质循环利用,符合循环原理,B不符合题意;
C、厨余垃圾堆肥发酵制成有机肥,将原本的废弃物转化为可被植物利用的养分,实现了废物资源化,符合循环原理,C不符合题意;
D、沙漠锁边工程选种本土植物,依据的是生态工程的协调原理(生物与环境相适应、符合环境承载力)和物种多样性原理,未体现物质循环的特点,D符合题意。
10.A
【详解】A、促肾上腺皮质激素是由垂体分泌的,下丘脑分泌的是促肾上腺皮质激素释放激素,A错误;
B、对比推拿组治疗前后的检测数据,皮质醇、促肾上腺皮质激素、促肾上腺皮质激素释放激素的水平均明显下降,接近健康组水平,说明推拿可以降低慢性失眠患者HPA轴相关激素的水平,B正确;
C、皮质醇含量升高时会通过负反馈调节抑制垂体分泌促肾上腺皮质激素,推拿后促肾上腺皮质激素和皮质醇水平均下降,推测推拿可能促进了皮质醇对垂体的反馈抑制作用,C正确;
D、慢性失眠会使患者出现疲劳、焦虑等症状,因此除相关激素水平外,还应检测睡眠质量、疲劳状态等指标综合评价治疗效果,D正确。
11.B
【详解】A、自身免疫病是免疫功能过强、攻击自身正常组织引发的疾病,抑制调节性T细胞会使两类T细胞活性进一步升高,加重自身免疫病症状,A错误;
B、细胞毒性T细胞可特异性识别并裂解癌细胞,抑制调节性T细胞可增强细胞毒性T细胞活性,强化对癌细胞的清除效果,减轻癌症症状,B正确;
C、移植排斥反应主要由细胞毒性T细胞攻击外来移植器官引发,抑制调节性T细胞会增强细胞毒性T细胞活性,加重排斥反应,C错误;
D、过敏反应是再次接触相同过敏原时发生的免疫过强反应,辅助性T细胞参与过敏反应过程,抑制调节性T细胞会增强免疫功能,加重过敏症状,D错误。
12.C
【详解】A、OsIAA7是生长素响应基因,GSK参与BR信号通路,二者共同调控水稻籽粒大小,A正确;
B、对比野生型和突变型,有OsIAA7时更多BZR被GSK磷酸化降解,说明OsIAA7能增强GSK对BZR的磷酸化修饰,B正确;
C、GSK的作用是促进BZR降解,osiaa7突变体籽粒增大的原因是BZR降解减少,若在该突变体中过表达GSK,会导致更多BZR降解,激活BR响应基因的BZR减少,籽粒会变小,而非更大,C错误;
D、该研究明确了水稻籽粒大小的调控通路,可通过靶向该通路获得大籽粒水稻,为水稻高产育种提供新靶点,D正确。
13.B
【详解】A、获取抗体基因时,可根据已知抗体基因序列设计引物,通过PCR技术特异性扩增得到目的基因,A不符合题意;
B、题干为基因工程方法,直接获取抗体基因导入噬菌体表达,不需要进行细胞融合,B符合题意;
C、要实现抗体展示在噬菌体表面,需要将抗体基因与噬菌体表面蛋白基因拼接为融合基因,使表达的抗体随表面蛋白共同呈现在噬菌体外壳上,C不符合题意;
D、抗原与抗体可特异性结合,因此可通过抗原-抗体杂交技术从噬菌体抗体库中筛选出携带目标抗体的噬菌体克隆,D不符合题意。
14.C
【详解】A、筛选分解尿素的细菌,原理是只有能利用尿素的细菌可以生长,因此培养基是以尿素为唯一氮源,不是唯一碳源,A错误;
B、对细菌数量进行计数需要采用稀释涂布平板法,平板划线法不能用于菌落计数,且图中菌落均匀分布,也不符合平板划线法的菌落分布特征,B错误;
C、稀释涂布平板法操作中,需要用无菌水对土壤浸出液进行梯度稀释,既可以避免杂菌污染,也能获得合适浓度的菌液,C正确;
D、微生物计数要求平板上的菌落数在30~300之间,图中菌落数符合该范围,可用于计数,D错误。
15.D
【详解】A、PCR扩增DNA包括变性、复性、延伸三个步骤,变性阶段高温使DNA双链解旋,之后降低温度可促进引物与模板单链互补结合完成复性,A正确;
B、低温可抑制纺锤体的形成,导致染色体不能移向细胞两极从而诱导染色体数目加倍,诱导洋葱细胞染色体数目加倍时可将其放置在4℃环境处理,B正确;
C、哺乳动物的正常体温约为37℃,体外培养哺乳动物细胞时需模拟其体内生理温度,通常以(36.5±0.5)℃为宜,C正确;
D、双缩脲试剂与蛋白质在常温下即可发生紫色反应,不需要放入沸水中加热,D错误。
16.(1)群落
(2)远低于夜蛾没有对云南蝇子草进行有效传粉
(3)信息传递限制单花产卵数,可降低夜蛾种内竞争,增加幼虫成活率;同时减少夜蛾对蝇子草果实的消耗
【详解】(1)生命系统的结构层次包括细胞、组织、器官、系统、个体、种群、群落、生态系统和生物圈。其中,群落水平研究的问题包括种间关系、优势种等,所以种间关系属于群落水平研究的问题。
(2)①据图可知,细蝇子草昼夜全套组的坐果率远低于其他三组。因为坐果率低,说明其高度依赖动物传粉。
②观察图中云南蝇子草不同套袋处理的坐果率,昼开夜套组(夜晚有传粉者,白天无)坐果率高于昼套夜开组(白天有传粉者,夜晚无),这表明夜蛾没有对云南蝇子草进行有效传粉,基于此研究者判断夜蛾与云南蝇子草的种间关系为寄生。
(3)细蝇子草释放挥发性化学物质吸引夜蛾传粉,此实例体现了生态系统中信息传递对于种群繁衍的重要作用。限制单花产卵数有利于维持二者互惠关系的原因是:限制单花产卵数,可降低夜蛾种内竞争,增加幼虫成活率;同时减少夜蛾对蝇子草果实的消耗,从而保证细蝇子草能成功繁殖后代,进而为夜蛾提供持续的传粉服务,维持二者的互惠关系。
17.(1)兴奋
(2)加入VLK组荧光强度显著高于对照组
(3)甲乙均无红色荧光带负电甲乙均有红色荧光
(4)仅作用于痛觉神经元,靶向性更强,副作用更少
【详解】(1)受到机械损伤时,感觉神经元会产生兴奋(神经冲动),兴奋传导至突触小体,引发VLK分泌到胞外。
(2)PLA技术中只有蛋白E与受体N相互靠近时才会产生红色荧光信号,图2显示加入VLK和PAP组无荧光,加入VLK组的荧光强度显著高于对照组,说明VLK可诱导E与N相互作用。
(3)组别2中蛋白E第504位氨基酸被替换成不可被VLK磷酸化的苯丙氨酸,无法带上负电荷,即使导入正常VLK基因,甲乙组也均无红色荧光,证明负电荷是相互作用的必要条件;组别3需将第504位替换为带负电的氨基酸,此时无需VLK磷酸化即可带负电,甲乙组均有红色荧光,证明负电荷是相互作用的充分条件。
(4)题干中VLK基因主要在痛觉神经元中表达,说明它在其他神经元中的表达量极低,几乎只在痛觉通路中发挥关键作用。因此以VLK为靶点的止痛药,能够优先、特异性地作用于痛觉神经元,而对其他神经元的正常生理活动影响极小;相比之下,氯胺酮(受体N阻断剂)会非特异性地阻断广泛存在于大脑和脊髓兴奋性突触的受体N,可能干扰多种神经元的功能。因此,以VLK为靶点的止痛药靶向性更强,副作用更少。
18.(1)细胞质基质
(2)L酶基因和P酶基因的mRNA含量
(3)L酶能抑制H蛋白的降解
(4)L酶抑制H蛋白降解并促进其入核,H蛋白含量升高使L酶、P酶更快合成。Wnt/β 连环蛋白信号通路通过正反馈机制,迅速提高有氧糖酵解速率,进而快速激活HSC
(5)β连环蛋白抑制剂/L酶抑制剂/H蛋白抑制剂
【详解】(1)葡萄糖分解为丙酮酸是细胞呼吸的第一阶段,该过程无论有氧无氧都发生在细胞质基质中。
(2)本实验探究Wnt信号通路对P酶、L酶基因表达的调节作用,因此用Wnt蛋白处理后,需要检测L酶基因和P酶基因的mRNA含量,实验结果符合“Wnt直接调节L酶基因、间接调节P酶基因表达”的推测。
(3)环己亚胺阻断了新蛋白质的合成,因此H蛋白含量的降低仅由降解导致;图3结果显示:L酶表达量越高,处理后剩余H蛋白含量越高,说明L酶可抑制H蛋白的降解,从而提高细胞内H蛋白含量。
(4)Wnt通路激活后,β连环蛋白直接促进L酶基因表达,L酶抑制H蛋白降解并促进其入核,H蛋白含量升高使L酶、P酶更快合成。Wnt/β 连环蛋白信号通路通过正反馈机制,迅速提高有氧糖酵解速率,进而快速激活HSC。
(5)该通路持续激活会促进HSC激活进而引发肝纤维化,因此可通过β连环蛋白抑制剂或L酶抑制剂或H蛋白抑制剂,抑制通路激活,从而抑制HSC激活,防治肝纤维化。
19.(1)免疫监视
(2)高表达的Tc细胞占全部Tc细胞的百分比:第1组-第2组>第3组-第4组
(3)M'M'AADD卵清蛋白肽段(呈递的抗原肽)、细胞因子
(4)
抑制Tc细胞对葡萄糖的摄取,抑制Tc细胞合成TNF
【详解】(1)从免疫系统的功能来看,免疫系统具有免疫防御、免疫自稳和免疫监视功能。肿瘤微环境中乳酸积累会减弱细胞毒性T淋巴细胞(Tc细胞)的杀伤能力,这使得肿瘤细胞能够逃避免疫系统的免疫监视。
(2)由题意可知,实验分为四组: 第1组为对照(无乳酸,无抑制剂),29.9% 的Tc细胞高表达 TNF;第2组仅乳酸处理,9.8%(明显下降);第3组仅用M蛋白抑制剂处理,45.2%(上升);第4组用乳酸+M 蛋白抑制剂处理,37.6%。其变化量为第1组-第2组=29.9%-9.8%=20.1%,第3组-第4组=45.2%-37.6%=7.6%,第1组-第2组>第3组-第4组,说明用乳酸+M蛋白抑制剂后高表达的Tc细胞占全部Tc细胞的百分比降低,表明乳酸可通过M蛋白抑制Tc细胞活性。
(3)①要获得 “仅在Tc细胞中M基因被敲除且Tc细胞能表达D受体” 的小鼠,需要同时满足:M基因两侧带LoxP 位点(M'M')、表达A基因(Cre重组酶,由T细胞特异性启动子驱动)、表达D基因(Tc细胞特异性抗原受体),因此需要获取基因型为M'M'AADD的纯合小鼠作为实验组。
②实验中D基因编码的抗原受体能特异性识别卵清蛋白肽段,因此需要用卵清蛋白肽段(呈递的抗原肽)、细胞因子处理,来活化Tc细胞。
(4)乳酸减弱Tc细胞杀伤能力的机制为:乳酸促进Tc细胞 M 基因表达→M 蛋白抑制Tc细胞对葡萄糖的摄取,减少能量供应→抑制Tc细胞合成TNF→Tc细胞的肿瘤杀伤能力减弱。
20.(1)紫茎
(2)A基因被甲基化修饰后不表达,不产生花青素
(3)rr
(4)F1中来自品系丙的甲基化A基因能够使来自品系甲的A基因甲基化,A基因表达受抑制,不产生花青素
子代全为绿茎
【详解】(1)根据杂交实验1,亲本为紫茎和绿茎,F1全为紫茎,F2中紫茎:绿茎=3:1。在遗传学中,具有相对性状的纯合亲本杂交,F1表现出来的性状为显性性状,所以可判断紫茎为显性性状。
(2)已知将编码去甲基化酶的R基因导入品系乙(绿茎)获得纯合转基因品系丁(绿茎),R基因与A基因不在同一对染色体上,品系丙与品系丁杂交,F1为紫茎,F2中紫茎:绿茎=3:1。由此推测品系丙表现为绿茎的原因是A基因被甲基化修饰后不表达,不产生花青素。
(3)在BCF1群体中,全绿茎群体占1/4,对应F₁产生的配子为“ar”,与品系乙(aarr)杂交后得到基因型为aarr 的个体,故该绿茎玉米与R/r相关的基因型为rr。
(4)由于F1(AaRr)中来自品系丙的甲基化A基因能够使来自品系甲的A基因甲基化,A基因表达受抑制,不产生花青素,因此连续自交后代仍全为绿茎。支持该假说的验证实验:将F1(AaRr,A甲基化)与品系乙(aarr)杂交,若子代全部为绿茎,则支持“甲基化导致A基因沉默且可遗传”的假说。
21.(1)转录
(2)使T7溶菌酶降解细菌细胞壁功能缺失;降低T7 DNA聚合酶的保真性
(3)质粒1质粒2质粒2
(4)AC
(5)仅针对外源目标基因进行突变,不导致宿主菌自身基因突变,宿主菌成活率高,目标基因持续超突变,进化速度快
【详解】(1)T7RNA聚合酶催化以DNA为模板合成RNA的转录过程,T7溶菌酶结合后,正在进行的转录过程终止,已合成的RNA可作为DNA复制的引物。
(2)T7溶菌酶的核心功能是降解宿主菌细胞壁,帮助子代噬菌体从细菌中释放,为实现持续超突变,需要使T7溶菌酶降解细菌细胞壁功能缺失,改造T7DNA聚合酶降低其复制保真度,提升突变频率。
(3)T7-OR系统仅使携带T7复制原点的质粒发生超突变。T7DNA聚合酶基因是系统的组成元件,不需要突变,因此构建在已有其他系统元件的质粒1上;目标基因β-内酰胺酶需要发生超突变,因此与T7复制原点一同构建在质粒2上。
(4)A、该系统本身可产生高突变率,同时大肠杆菌繁殖速度快,能快速传代积累突变,实现目标基因快速高频突变,A正确;
B、基因突变是不定向的,该过程是不定向突变后,通过抗生素筛选获得功能提升的突变体,并非定向突变,B错误;
C、进化出的突变位点和临床耐药菌株高度一致,说明该实验结果可反映真实的进化规律,具备实用性,C正确。
(5)传统诱变是全基因组随机诱变,突变效率低、筛选难度大;该系统靶向目标基因突变,仅针对外源目标基因进行突变,不导致宿主菌自身基因突变,宿主菌成活率高,目标基因持续超突变,进化速度快。